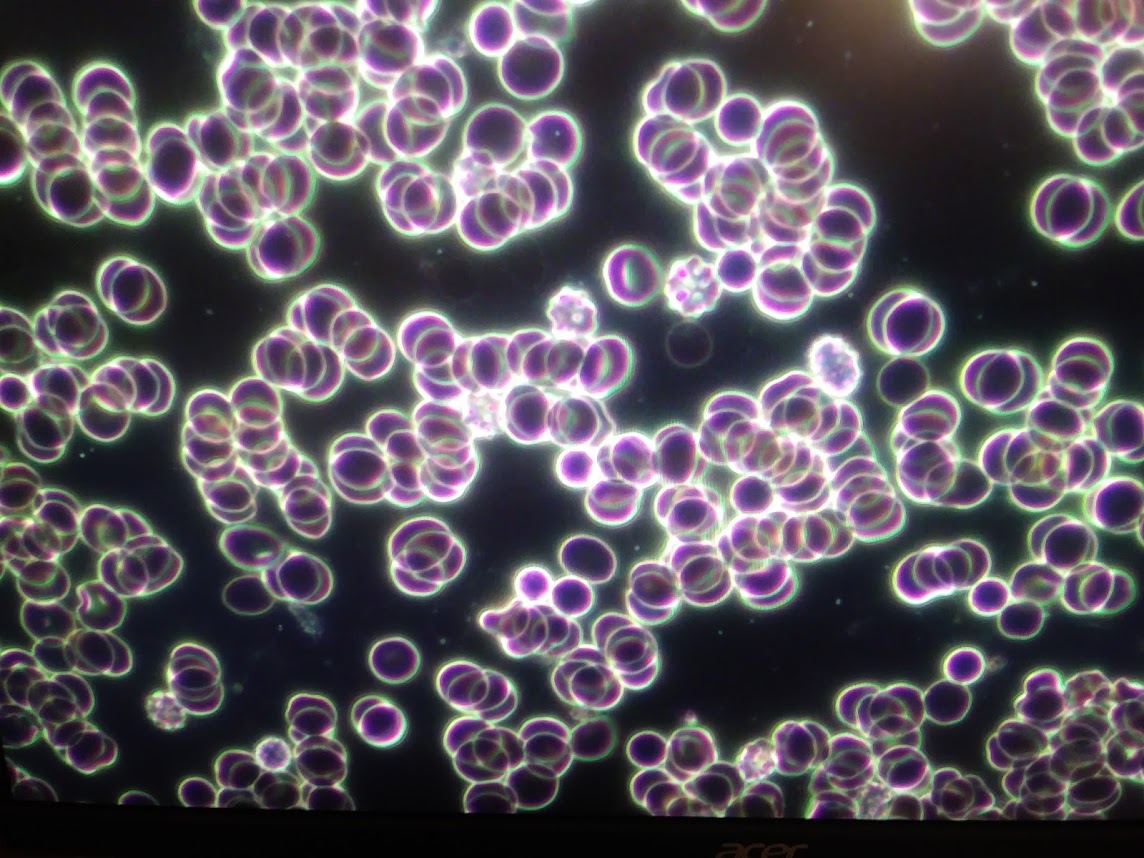

Understanding Your Body in Real Time
Live blood analysis from a biologist & certified sports nutritionist.
Live blood analysis from a biologist & certified sports nutritionist.
At KAMM Nutrition, our mission is to give you control over your health by showing you what’s happening in your body — right now.
We use real-time blood analysis and a science-backed, holistic approach to help you understand how your lifestyle, diet, and habits are affecting your health.
No confusing labs. No fluff. Just the truth — clearly explained.
Kenny is a trained biologist, certified nutritionist, and experienced physical trainer.
He specializes in live blood analysis using a painless finger prick — no needles or labs.
With a single drop of blood, Kenny reveals insights into deficiencies, dehydration, inflammation, and more — all displayed in real time on a monitor.
His goal is simple: help you understand your body in plain language, and give you practical ways to feel your best using natural remedies, movement, and nutrition.
In just 10 minutes, we show you what’s happening inside your body — live on screen.
1. A small finger prick (like a glucose test)
2. Blood placed under a high-powered microscope
3. Live analysis projected onto a monitor
4. Kenny walks you through what he sees — in real time
Each session is personalized, judgment-free, and focused on helping you feel your best through natural solutions— no prescriptions, no pressure.
Real-time results you can actually see
No labs, no waiting — just a finger prick
Explained in real, honest language
Custom wellness advice — no pressure, no gimmicks
Science-backed supportwith a personal touch
Not at all. We only need a tiny drop of blood from a quick finger prick. It’s painless, fast, and you see your results live on screen — no waiting.
Live blood analysis is a powerful observational tool that offers insights into hydration, immune function, inflammation, and more. It’s not a medical diagnosis, but it’s incredibly useful for understanding your body and how to support it.
Kenny gives you personalized advice you can use right away — including natural remedies, supplement tips, and lifestyle suggestions based on what he sees in your blood.